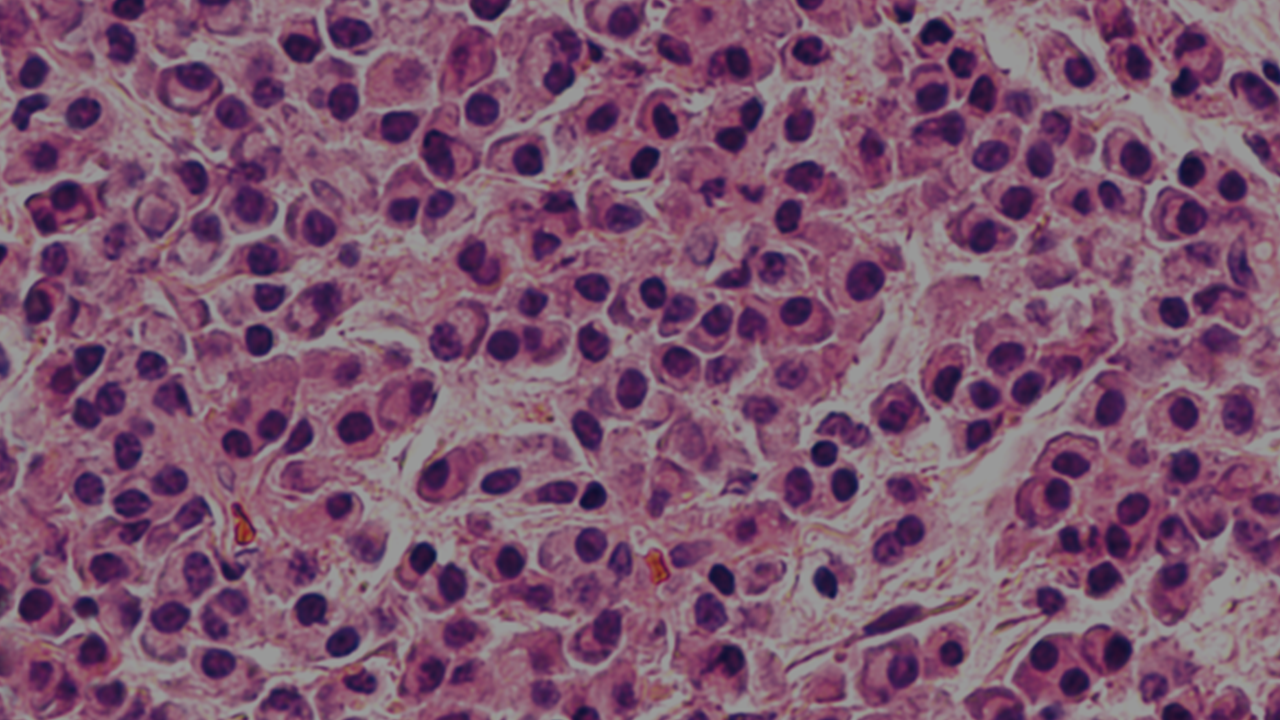

A diagnosis of Multiple Myeloma (MM) is based on a number of clinical features and biomarkers. This page will explore the investigative work in more detail.
Symptoms in MM are often vague and include musculoskeletal pain and tiredness. The presentation of symptoms, the course of the disease and the clinical behaviour vary greatly from patient to patient. Due to this heterogeneous nature it may be challenging for general health practitioners (GPs) to decide on when to refer patients with MM to a haematologist or hospital. As a result, MM patients are more likely than other cancer patients to have three or more GP visits before their referral. The other route of diagnosis is through emergency diagnosis which is usually associated with poorer outcomes.
CT, computed tomography; FISH, fluorescence in situ hybridisation; FLC, free light chain; Ig, immunoglobulin; M, monoclonal; MRI, magnetic resonance imaging; PET-CT, positron-emission tomography with computed tomography
Disease presentation and progression can vary significantly from patient to patient. These symptoms are referred to as CRAB (Calcium (elevated), Renal impairment, Anaemia and Bone disease).
Less common symptoms (occurring in 5% of patients) include extramedullary soft-tissue plasmacytomas or spinal cord compression following vertebral fractures. Patients may also present with recurring bacterial infections, with about one-third of patients diagnosed following investigation of elevated erythrocyte sedimentation rate, total protein or immunoglobulins. Patients with increased monoclonal (M) protein can experience headaches, nose bleeds, confusion and blurred vision.
Some patients may consult their GP because of non-specific symptoms such as fatigue or back pain, while others may present at the emergency room with acute symptoms such as a long bone fracture or spinal compression.
The diagnosis of smouldering MM requires the following criteria to be met:
Not all patients with MM have M-protein in their serum or urine. For this reason, the presence of M-protein is not required for a diagnosis of MM; rather, it is used to differentiate between secretory and non-secretory types.
Although each patient may present very differently, the diagnosis of symptomatic MM requires a number of specific criteria.
Patients should have at least 10% clonal bone marrow plasma cells or biopsy-proven bony or extramedullary plasmacytoma, and any one or more myeloma-defining events (CRAB and/or biomarker of malignancy).
CRAB criteria providing evidence of end-organ damage related to the underlying plasma cell disorder:
Any one or more biomarkers of malignancy:
Even with significant advances in treatment, MM remains a challenging disease. Find out more about the evolution of MM.
The right treatment plan can improve a patient treatment response. Find out how treatment response is measured and what strides are being taken to optimise it.